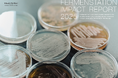
ファーメンステーション、2025年度のインパクトレポートを公開

プレスリリース一覧
- 表示切り替え

会員制フレンチで味わう、仲春の六皿。最大4名で楽しめるサブスクレストラン『Provision』が4月のマンスリー...
INSTYLE GROUP
ファーメンステーション、2025年度のインパクトレポートを公開
株式会社ファーメンステーション
【展示会出展】VIA、Japan IT Week 春 2026 にて次世代エッジAIプラットフォームを一挙公開
VIA Technologies Japan株式会社
メディア関係者の方のみご覧頂けます
アサヒグループ食品株式会社
【KATHARINE E HAMNETT】上質なブリティッシュウール混で夏も涼しく、美しく。サステナブルかつ高機能な「キ...
株式会社はるやまホールディングス
東京都「豊洲 千客万来」に“圧縮する”スマートゴミ箱「SmaGO」を導入
フォーステック
【Beyondが第2種旅行業免許を取得】高付加価値体験プラットフォーム「Origami Concierge」、宿泊・移動を含む...
株式会社Beyond(ビヨンド)
【KATHARINE E HAMNETT】 驚異の耐久性と軽さを両立!サステナブルな「コーデュラ®セットアップ」が新登場!
株式会社はるやまホールディングス
成蹊大学、4月25日に講演会 「生成AIを仕事や学業に活かすコツ 」を開催
学校法人成蹊学園
累計8万人が受検の「DX検定」が国の基準に準拠、DX Next検定(TM)」として大幅リニューアル
NET
アスエネ、経団連後援のオンラインセミナーを開催。東京大学・江守正多教授とCEO西和田浩平が登壇
アスエネ株式会社
クラウド型ETLツール「Reckoner」、サイボウズのパートナー評価制度「CyPN Report 2026」アライアンス部門に...
株式会社スリーシェイク
『勝利の女神:NIKKE』最新バージョン「GOOD WORLD」まもなく実装!合わせて展開されるアニスのサイドストー...
Level Infinite
【 iLect Academy 2026 】AI総合研究所NABLASが提供する、JDLA認定ディープラーニング講座「DL4E 2026 Summer...
NABLAS株式会社
公益財団法人横浜市観光協会は横浜市SDGs認定制度「Y-SDGs」上位認証のSuperiorを取得しました!
(公財)横浜市観光協会
いろどり、のびやか『胡粉ネイル2026春の新色』4月10日より販売開始
上羽絵惣株式会社
贈り物のお菓子を選ぶとき、どうやってお店を探すのか?〜消費者アンケートで紐解く「今どきの調べ方」と「ク...
株式会社カンリー
剥離リサイクル技術によりアルミパウチの再資源化を実現 DHCサプリメントの包装袋が新たな包装資材に生まれ...
artience株式会社
【深夜の買い物に関する実態調査】深夜1時は「理性がログアウト」する魔の時間帯。24kgの漂白剤、3kgの牡蠣…...
株式会社HADO
【カオピーズ】Japan IT Week【春】2026 「DX・AI・クラウド個別相談会」予約受付開始!
株式会社カオピーズ
岩手県遠野市とバイウィルが「カーボンニュートラルの取組みに関する連携協定」を締結
株式会社バイウィル
【初開催】クリエイト礼文、平屋特化イベントを実施|来場者限定で“未公開のリアル間取り”を公開
株式会社クリエイト礼文(ユニテハウス)
ユニファースト、採用サイトに「橋本社長AI」を公開 ― 社長と対話する、新しい採用体験 ― 対話を通じて、企...
ユニファースト株式会社
【母の日ギフト】SNSで人気の”枯れない花”モールフラワー専門店「hanamaru flower」が日本橋三越本店にてカー...
hanamaru flower
国内外総店舗数「100店舗」 ハンズ イオンモール太田店 6月18日(木)オープン
株式会社ハンズ
バイウィルがコニカミノルタ「環境デジタルプラットフォーム」の初の外部ファシリテーターに就任。“実践企業...
株式会社バイウィル
【木村屋總本店】<新商品>“おむすび”そっくりのかわいい惣菜パン「おむすびパン(鮭×クリームチーズ)」新発売!
株式会社木村屋總本店
ワイヤレス充電は「25W」の領域へ。最新規格Qi2.2認証、世界最小級3-in-1充電器「P1 mini」が国内先行予約で...
Redbean | レッドビーン
Open8 Private Summit 2026 〜HRコミュニケーションカンファレンス〜 開催
株式会社オープンエイト
D.LEAGUE新チームオーディション 「NAIL the NAME」で最終審査が大会内で開催!最終選考メンバーによる初のパ...
株式会社アノマリー
社保料・税金滞納で倒産、2025年度は221件 過去2番目の高水準 ほぼ全件で「破産」 滞納後の事業再建、難易...
株式会社帝国データバンク
世界最大級AI映画祭で受賞|GOKKO所属クリエイターがWAIFF 2026 KYOTOで審査員特別賞を獲得
ごっこ倶楽部
《今年も登場!》韓丼の初夏を彩る“ひんやり仕立て”さっぱりコク旨『韓国冷麺』&旨辛やみつき『ビビン冷麺』
株式会社やる気
【BUZZ下北沢】待望の下北沢エリアに上陸!全6スタジオ・下北沢駅徒歩3分!30分300円〜で24時間使えるレンタ...
株式会社BUZZ GROUP
株式会社RECOREが「FaW TOKYO春」に出展決定
株式会社RECORE
2025年版カジュアルゲーム最新動向調査 ―パズルが46.6%を占有、オリジナル作品が9割
株式会社スパイスマート
「はんにゃ.」金田さんの応援メッセージやマーク・パンサーさんがサプライズ登場!
三共食品株式会社
もしもに備えて安心を。マンション用防災ツール「First Mission BoxⓇ」新築分譲マンションデュオヒルズ六甲道...
株式会社フージャースホールディングス
DeepL調査:日本企業、業務時間の約2割を「言語対応」に費やす
DeepL
